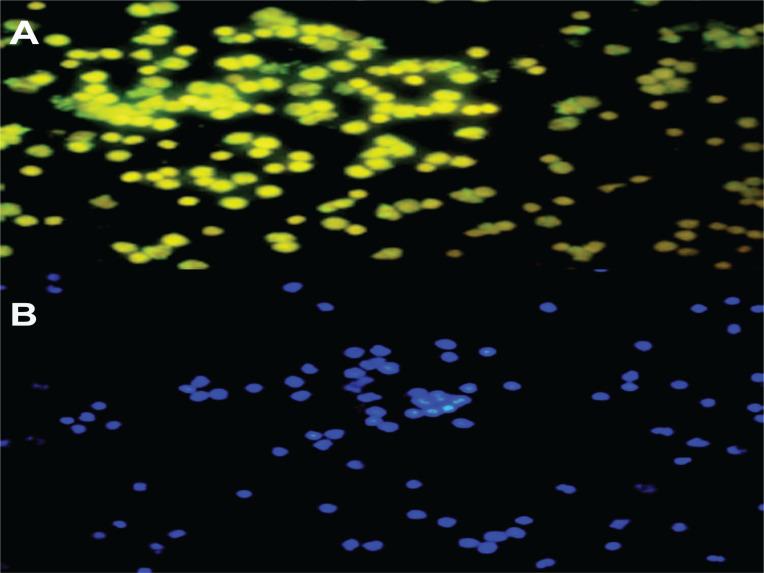

非吸烟者和吸烟者晚期内皮祖细胞衰老的差异。
Differences in senescence of late Endothelial Progenitor Cells in non-smokers and smokers.
作者信息
Kumboyono Kumboyono, Chomsy Indah Nur, Nurwidyaningtyas Wiwit, Cesa Fibe Yulinda, Tjahjono Cholid Tri, Wihastuti Titin Andri
机构信息
School of Nursing, Faculty of Medicine, University of Brawijaya, Malang, Indonesia.
Faculty of Medicine, University of Brawijaya,Malang, Indonesia.
出版信息
Tob Induc Dis. 2021 Jun 2;19:10. doi: 10.18332/tid/135320. eCollection 2021.
INTRODUCTION
Endothelial Progenitor Cells (EPCs) are part of hematopoietic stem cells that differentiate into endothelial cells during their blood vessels' maturation process. The role of EPCs is widely known to contribute to repair of the vascular wall when endothelial dysfunction occurs. However, various risk factors for cardiovascular disease (CVD) influence EPC performance, leading to endothelial dysfunction. One EPC dysfunction is decreased amount of EPC mobilization to the injured tissue. EPC dysfunction reduces the angiogenetic function of EPCs. The vital maturation process that the EPCs must pass is the late phase. The dysfunction of late EPCs is known as senescence. This study aimed to identify and compare senescence of late EPCs, through CD62E and CD41 markers, in non-smokers and smokers as a risk factor for CVD.
METHODS
EPC collection was from peripheral mononuclear cells (PBMCs) in non-smokers (n=30) and smokers (n=31). The EPCs were then marked by CD62E/CD41 and senescence β-galactosidase assay using FACS. Identification of senescence cells was based on fluorescence with DAPI.
RESULTS
Positive percentage of late EPCs in non-smokers was not significantly different from that in smokers (p=0.014). The number of senescent late EPCs in smokers was higher than in non-smokers (p<0.0001).
CONCLUSIONS
Endothelial progenitor cells that experienced senescence in the smokers showed EPC dysfunction, which resulted in decreased cell angiogenic function. Further research is needed to explain the mechanism of re-endothelialization failure in EPC dysfunction due to smoking.
引言
内皮祖细胞(EPCs)是造血干细胞的一部分,在血管成熟过程中分化为内皮细胞。众所周知,当内皮功能障碍发生时,EPCs在血管壁修复中发挥作用。然而,心血管疾病(CVD)的各种危险因素会影响EPCs的性能,导致内皮功能障碍。EPCs功能障碍的一个表现是其向损伤组织的动员数量减少。EPCs功能障碍会降低其血管生成功能。EPCs必须经历的关键成熟过程是晚期阶段。晚期EPCs的功能障碍被称为衰老。本研究旨在通过CD62E和CD41标记物,识别和比较非吸烟者和吸烟者中晚期EPCs的衰老情况,吸烟者是CVD的一个危险因素。
方法
从非吸烟者(n = 30)和吸烟者(n = 31)的外周血单个核细胞(PBMCs)中收集EPCs。然后使用流式细胞术通过CD62E/CD41和衰老β-半乳糖苷酶测定对EPCs进行标记。衰老细胞的鉴定基于DAPI荧光。
结果
非吸烟者中晚期EPCs的阳性百分比与吸烟者相比无显著差异(p = 0.014)。吸烟者中衰老晚期EPCs的数量高于非吸烟者(p < 0.0001)。
结论
吸烟者中经历衰老的内皮祖细胞表现出EPCs功能障碍,导致细胞血管生成功能下降。需要进一步研究来解释吸烟导致EPCs功能障碍时再内皮化失败的机制。